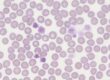

Questo gruppo di patologie nel cavallo comprende malattie parassitarie croniche, ulcere gastrointestinali, malattie infiammatorie croniche e linfoma del tratto alimentare.
Tutte queste affezioni determinano una perdita cronica di proteine nel lume o un loro mancato assorbimento, con o senza diarrea. Sono quasi sempre accompagnate da perdita di peso cronica. L’appetito può essere invece conservato o capriccioso. Inoltre, possono esserci episodi colici, letargia o debolezza.
Parametri ematobiochimici generali
Prendiamo in considerazione i principali parametri ematobiochimici che possono indirizzarci verso questo tipo di diagnosi:
- esame emocromocitometrico: potrebbe essere presente anemia rigenerativa associata ad un leggero rialzo della serie bianca (eosinofili o linfociti) con ematocrito molto basso; se presente diarrea potrebbe esserci invece emoconcentrazione
- proteine totali / elettroforesi: in generale si riscontra ipoproteinemia con ipoalbuminemia ed ipoglobulinemia; nelle forme croniche o neoplastiche possiamo avere anche iperglobulinemia
- fosfatasi alcalina e creatinchinasi: sono spesso aumentate a causa dell’intenso catabolismo muscolare dovuto al deficit energetico
- GGT e bilirubina totale: possono essere aumentate in caso di patologia epatica o molto diminuite a causa del deficit delle proteine plasmatiche circolanti
- fibrinogeno / siero amiloide: possono risultare elevate se l’ipoalbuminemia non è grave.
Malattie parassitarie croniche
Alcuni soggetti particolarmente predisposti possono sviluppare un’infiammazione cronica subclinica per effetto della presenza di endoparassiti, nonostante protocolli di sverminazione rigorosi. Questa infiammazione, protratta negli anni, potrebbe favorire lo sviluppo di enteropatie croniche infiammatorie che facilmente portano a malassorbimento.
Un controllo fecale regolare con conta delle uova per grammo di feci (metodica McMaster) per tenere sotto controllo la carica parassitaria e valutare lo sviluppo di resistenza antielmintica – oltre ad una corretta pulizia e rotazione dei pascoli – appare indispensabile per questi soggetti, in modo da modulare efficacemente i protocolli di sverminazione, specialmente quando sono presenti molti cavalli nella struttura.
- Cyatostomiasi da forme larvali incistate: nel caso di infestazione da piccoli strongili che possono incistarsi, specialmente nell’ultimo tratto di intestino, il carico di uova nelle feci potrebbe essere comunque basso, pertanto si consiglia un esame microscopico diretto di visualizzazione delle larve stesse nelle fiande, possibilmente dopo un prelievo diretto dall’ampolla rettale, massaggiando le pareti
- Tenia sp.: l’escrezione di uova o proglottidi nelle feci per questi parassiti è intermittente, un esame coprologico quindi (flottazione e S.A.F.C.) non appare affidabile per una diagnosi certa, pertanto la decisione di trattare per questo parassita va presa sulla base dell’anamnesi e della sintomatologia.
Ulcere gastrointestinali
La presenza di gastrite e / o ulcere gastriche nel cavallo dà origine ad una sintomatologia vaga ed aspecifica, non correlata alla gravità del danno mucosale: disoressia, colichette ricorrenti, calo di peso, mantello opaco, sbadigli, diarrea intermittente e, come rilievi di laboratorio, ipoproteinemia / ipoalbuminemia.
Il presidio diagnostico di elezione in questi casi è rappresentato dalla gastroscopia o da un’ecografia addominale, vediamo però quale parametro di laboratorio può venirci in aiuto qualora questi esami non siano un’opzione percorribile.
- Sangue occulto nelle feci: si tratta di un test che rileva in modo molto generico la presenza di infiammazione con soluzione di continuità della mucosa e stillicidio di sangue nel tratto gastroenterico, senza però fornire alcuna indicazione utile per la localizzazione del problema. Purtroppo, l’elevata quantità di materiale fecale prodotto da un equino nell’arco della giornata e le notevoli dimensioni del canale alimentare, rendono molto probabile la degradazione del sangue lungo questo percorso da parte dei numerosi batteri della flora digestiva, abbassando di molto l’attendibilità di questo esame. Per questo motivo un esito negativo non esclude la presenza di lesioni, soprattutto se a carico del primo tratto. Ugualmente, un esito positivo non permette comunque di localizzare con precisione quale parte di mucosa risulti danneggiata. Esistono anche in commercio dei kit per effettuare questo esame in campo.
Malattie infiammatorie croniche intestinali (CIBD)
Si tratta di un gruppo di enteropatie caratterizzate dall’infiltrazione di mucosa e sottomucosa da parte di cellule della serie bianca (eosinofili, linfociti, plasmacellule e macrofagi) che possono colpire sia il piccolo che il grosso intestino.
Questi infiltrati determinano un’alterazione ad andamento cronico progressivo della funzione degli enterociti con atrofia dei villi, testimoniata da un generico malassorbimento accompagnato da disbiosi, responsabili della sintomatologia aspecifica prevalente: dimagrimento cronico senza grosse variazioni di appetito, diarrea ricorrente o feci poco formate, a volte lieve dolore addominale. Nei casi gravi questi infiltrati possono alterare ed ispessire la mucosa causando blocchi da ostruzione e grave decadimento della condizione corporea.
Il sistema immunitario presente nel tratto intestinale è continuamente stimolato da allergeni alimentari, batteri e parassiti che vengono introdotti nell’arco della vita. Questo comporta che vi sia un equilibrio delicato tra tolleranza ed infiammazione subclinica della mucosa che, per cause ancora poco conosciute, può alterarsi e determinare l’insorgenza della malattia.
Come regola generale, sappiamo che un’alterazione del microbioma, una dieta ricca di carboidrati, la presenza cronica di parassiti intestinali e, non da ultimo, una predisposizione genetica, giocano tutti un importante ruolo nello sviluppo della patologia.
- Ecografia addominale: con questo esame potrebbero evidenziarsi degli ispessimenti della parete del piccolo e grosso intestino (> 3 mm) ed ingrossamento di alcuni linfonodi addominali.
- Test di assorbimento orale del glucosio: questo test funzionale permette di diagnosticare l’inabilità della mucosa di assorbire efficacemente questo zucchero e, conseguentemente, confermare il danno mucosale dato da questa patologia.
(vedi approfondimento 2020 “Diagnostica di laboratorio dell’apparato gastroenterico: sindromi da malassorbimento (2)”)
- La diagnosi di conferma si può avere dopo esame istologico da biopsia duodenale tramite gastroscopia, oppure da biopsia rettale, anche se quest’ultima appare non sempre diagnostica in quanto presa “alla cieca”. È indicata anche una biopsia intestinale da laparotomia dal fianco od intraoperatoria, che permette di localizzare i prelievi nelle zone di mucosa alterata, con maggiore probabilità di diagnosi.
I reperti istologici diagnostici comprendono un’infiltrato infiammatorio composto da eosinofili, ma anche linfociti o plasmacellule, localizzato in più di uno strato epiteliale.
Linfoma alimentare
Questa neoplasia potrebbe presentarsi sia come una massa tumorale singola o multifocale che come un infiltrato multicentrico di tutto il tratto intestinale.
- Amiloide sierica / calcio / fosfatasi alkalina: sono parametri aspecifici che potrebbero innalzarsi in questi casi, come risultato di una cosiddetta sindrome paraneoplastica.
- Elettroforesi delle proteine: il tracciato elettroforetico appare di solito anomalo per la presenza di picchi monoclonali o policlonali delle gammaglobuline prodotte da proliferazioni incontrollate di un singolo clone o più tipologie di cellule neoplastiche; nelle forme più gravi possiamo addirittura avere una iperproteinemia da iperglobulinemia accanto ad un’ipoalbuminemia grave.
- Timidin chinasi: si tratta di un biomarker diagnostico per il linfoma nel cavallo poiché aumenta nel siero in maniera decisiva nel corso delle divisioni cellulari di tipo neoplastico. E’ stato validato in questa specie come diagnostico per linfoma, anche se lievi aumenti potrebbero verificarsi in caso di neoplasia di altra natura od infiammazione cronica.
- Citologia del liquido peritoneale: in alcuni casi l’esame citologico del liquido peritoneale potrebbe rilevare la presenza di cellule della serie bianca neoplastiche, dopo opportuno citospin. Un’alternativa potrebbe essere effettuare un agoaspirato ecoguidato da un linfonodo patologico, anche se la diagnosi definitiva in questi casi il più delle volte è purtroppo post-mortem.
Dott.ssa Susanna Mereghetti